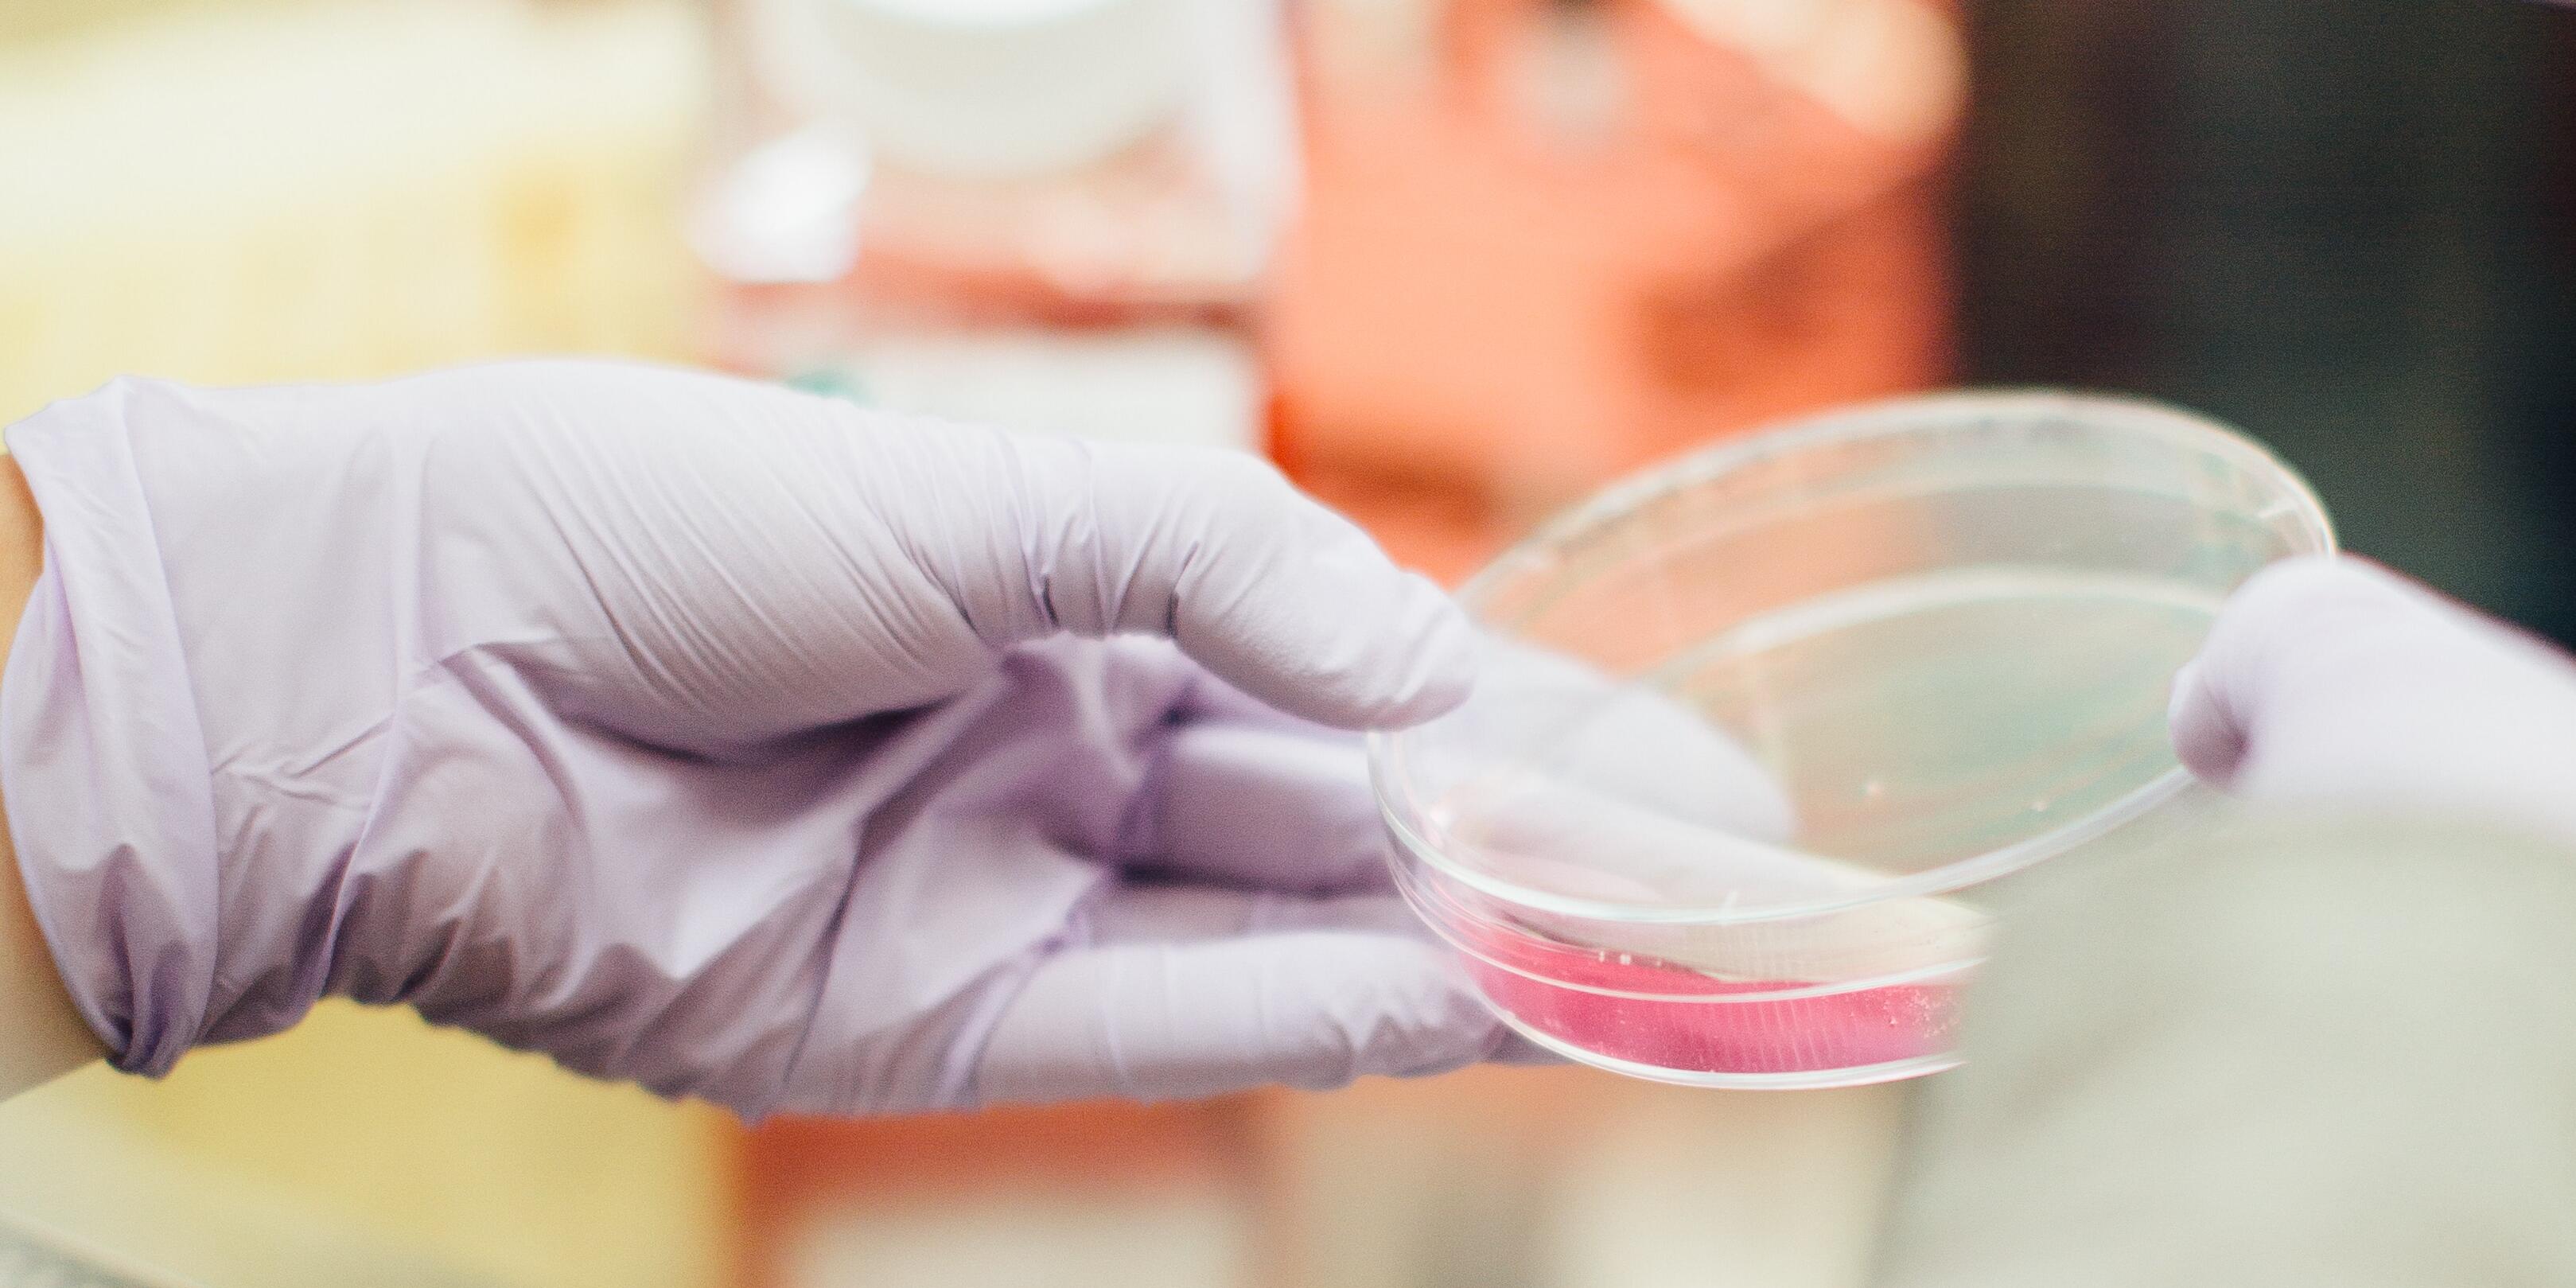

News archive


7th Chembion Symposium


Focus on retinal diseases - BMFTR funding for nanoparticle research

Student exchange with South Korea – Report by Martha Marquardt


Jens Münchow becomes West German Science Slam Champion 2025


„GA Discovery Award“ for Justus Mukavi


Travel Grant for Ms. Chiara Maria Hensen


APV Travel Grants


Certificate Ceremony and Farewell Celebration at the PharmaCampus Münster


Frontiers in Medicinal Chemistry


6th Chembion Symposium


22. PharmSchool-Symposium


Medicinal plant of the year


DPhG Annual Meeting 2024: Poster awards

University of Münster hosts the DPhG Annual Meeting

Evaluation Award "Goldener Spatel"

Professor Dr. Denise Steiner presents her research

Fabian C. Herrmann habilitated

Verspohl Foundation awards study scholarships

Infection Biology and Natural Products: Challenges and Opportunities

Interprofessional teaching at PharmaCampus

Dates in the garden year 2024


Dissertation award for Dr. Janosch Menke

Extension of the Research Training Group "Chembion"

Study of pharmacy and industrial practice

Graduation ceremony 2nd State Examination Pharmacy

REACH SCIENCE TO START-UP CONVENTION

Rottendorf-Stiftung zeichnet zwei junge Wissenschaftler aus
Announcement of two positions for doctoral theses

CIC Award for Computational Chemistry

Evaluation Award "Goldener Spatel"

19th PharMSchool Symposium






























